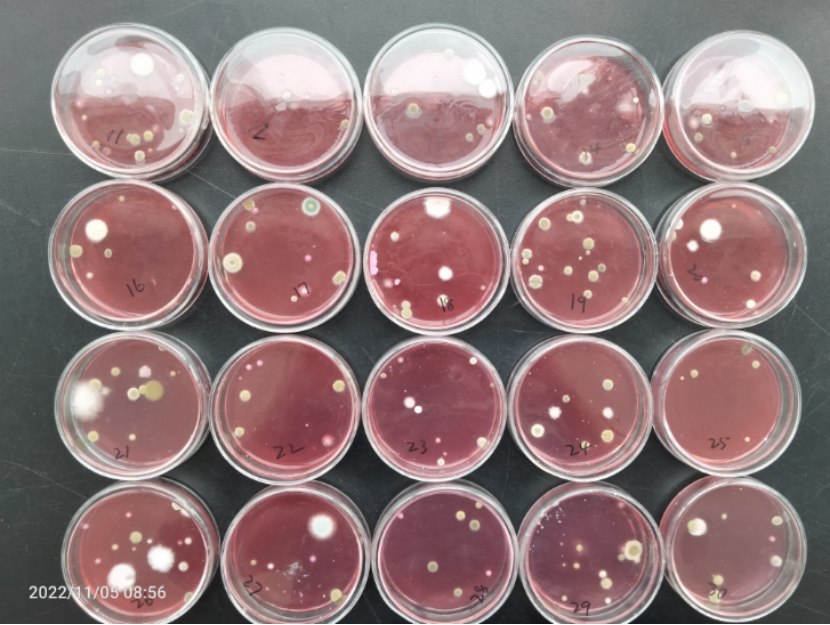
孟加拉红培养基监控霉菌/酵母菌空气沉降效果图

食品工厂空气沉降菌监测5个关键步骤和注意事项
发布时间:2024-09-23 浏览次数:1783
食品加工厂空气环境条件,对食品生产的质量影响巨大。空气中除了含有大量的尘埃还存在大量的微生物。在这样的环境条件下进行食品生产,肯定会对食品造成污染。要想杜绝带有大量尘埃微粒和微生物的空气污染食品,就要对空气采取过滤和消毒措施。同时,要定期或者不定期进行监测来确定是否满足生产要求。微生物的监测频次、如何测试,测试结果如何统计、计算和分析,怎么才算合格。这一系列问题经常在各大微生物检测群探讨。
环境微生物的监控主要有三个部分的内容:
食品接触表面:包括食品加工人员的手部、工作服、手套、传送带、工器具及其他直接接触食品的设备表面的菌落总数和大肠菌群。
与食品或食品接触表面邻近的接触表面:包括设备外表面、支架表面、控制面板、零件车等接触表面的菌落总数和大肠菌群,必要时监测致病菌。
加工区域内的环境空气:靠近裸露产品的位置。主要监测菌落总数、霉菌酵母菌。
关于这项工作,在食品安全国家标准GB 14881-2013《食品生产通用卫生规范》中有明确规定。对于监控频率、监控指标限值的建议和设定的依据亦有详细说明。
详见附件A:

环境空气微生物监控方法有两种,一种是测试空气沉降菌(自然沉降法),另一种是测试空气中的浮游菌(撞击法)。
食品加工区域内环境空气微生物的测试方法,没有直接的国家标准。具体操作方法,可以参照GB/T 16294 医药工业洁净室(区)沉降菌的测试方法和GB/T 16293医药工业洁净室(区)浮游菌的测试方法。还可以参考相关专业教课书上教授的方法,以及参考文献上介绍的方法。总的来讲,国家标准是强制性的,所有的同一类型的行业和机构必须统一使用;推荐标准则是在制定国家标准的水平和条件还不成熟的情况下,临时推荐或者介绍的一种或几种检测方法供使用者参考。
它不是强制性必须使用的,换句话说,你可以使用也可以不使用。如果你感觉所推荐的方法比较低级落后,可以去查阅参考文献,了解国际上最先进的方法去学习并加以使用。
对于食品加工区域内环境空气微生物的测试 ,测试空气沉降菌和测试空气中的浮游菌,哪一种方法比较实用呢?有人专门在化妆品车间用两种不同的方法做了对比试验,并撰写了论文《自然沉降法和撞击法在空气细菌总数测定中的应用和比较》[1]。
文章中研究结果显示:无论是静态环境(生产前)还是动态环境(生产中),自然沉降法测定的菌落总数经奥梅尔良斯基公式转换后所得的单位空气体积内的细菌总数结果其中位数(均值)大于撞击法同步采样所得空气细菌总数;撞击法测得的空气细菌总数合格率高于沉降法所测得的空气细菌总数合格率。
换句话说,就是在同样条件下用撞击法测得的结果可能是合格的,而用沉降法去测定就可能不合格。从另一个角度可以理解为沉降法测得的结果要严于撞击法。
基于上述结论,所以说,对于食品加工厂空气环境微生物的监测方法个人推荐沉降法。
沉降法操作相对简单,而撞击法需要购买专门的空气微生物采样器,这个空气微生物采样器需要定期维护保养,每年还需要到计量部门进行校准。
下面根据自己多年的经验,重点谈一下食品加工厂环境微生物监测中的沉降菌法中的关键步骤注意事项。
一、采样点设计
采样点的布局应该分布均匀,理论上采样点越多越好,要根据车间面积大小的具体情况一般不少于9个,这样才符合统计学调查的要求,最大限度地接近客观实际情况。
一般采用棋盘格式布局,实验前确定需要监控的环境空间,可以是XX车间、XX包装间、XX库房。根据具体情况设计采样点布局图,图中的数字代表放置培养皿的个数和位置。考虑到边际效应,培养皿的摆放距离墙壁至少1米。

图1 九个采样点布局图

图2 十五个采样点布局图
二、关于空降暴露时长

根据GB/T 16294-2010关于沉降菌技术要求,培养皿暴露时间不超过4h,经过实践检验验证,培养皿暴露20 min效果比较稳定。
实验一般选择在生产中(生产后1h)进行,这样才能模拟出在生产活动中空气微生物对产品的污染情况。因为采集的空气当中的微生物是靠重力自然沉降并用培养皿俘获的,这个沉降的时间是比较缓慢的,如果沉降个5 min、10 min,时间较短,空气中的微生物没有足够的时间沉降到培养皿中。
如果设计沉降时间1~4 h,不仅需要耐心的等待,还影响生产。还有一个重要的因素就是沉降时间过长,培养皿俘获的微生物就过多,导致培养后计数困难,同样影响到结果的准确性。
三、培养基种类的选择
GB/T 16294-2010中推荐使用的大豆酪蛋白琼脂培养基(TSD)或沙氏培养基(SDA)或用户认可并经过验证了的培养基。TSD和SDA培养基是推荐在医药工业洁净区使用。
对于食品加工厂级洁净区,还是建议使用我们常用熟悉的培养基,菌落总数平板计数培养基(PCA)、大肠菌群平板培养基(VRBA),如果测霉菌/酵母菌就用马铃薯葡萄糖琼脂培养基(PDA)或者孟加拉红培养基。
培养皿选择∮90 mm规格的,皿盖写上编号,和采样点布局图上的编号一一对应。这样,一旦某个培养皿出现异常数据,可以核对采样点布局图,确认具体的采样位置,分析出现异常数据的原因。
图3 孟加拉红培养基监控霉菌/酵母菌空气沉降效果图
四、结果统计分析
结果计算方法按照GB/T 16294-2010推荐的方法:

这里要注意的是,根据上述公式得出的结果只是在指定的暴露时间内的结果,并不是最终的评定结果。为了排除异常数据,在计算的过程中还要去掉一个最大值和一个最小值。
根据GB/T 16294-2010附录c,要把暴露时间折算成4h,比如:设定的暴露时间为20 min,则需要把根据上述公式得出的数据再乘以12,才是最终评定需要的结果。
五、异常数据的出现及原因分析
在生产过程中测试空气中的沉降菌,由于被测试的空间并非理想空间。空间内的温度分布不均、机械设备的运转、人员的走动等,都会引起空气的乱流,因此导致空气中的微生物在下落的过程中,不会象自由落体运动那样直上直下地均匀的落到培养皿中,而是随机的落到培养皿中。
还有就是可能培养皿放置的位置可能处于死角,没有俘获到微生物或者极少。人员的走动可能把地面的水滴溅到培养皿里,天棚上的霉层也可能脱落一簇霉菌的孢子恰好掉到培养皿里,造成菌落蔓延或多不可计。因此可能产生异常数据,所以在数据的统计过程中要去掉一个最大值和一个最小值尽量减少结果的偏离。
另外培养皿要放在离墙一米以外的位置,也是为了防止边际效应,影响到结果的准确性。
六、结果评定
对于监测结果的评定标准可以参考GB/T 16294-2010附录c,也可以依据GB 14881中的表A.1,结合生产实际情况确定监控指标限值来评定结果是否合格,在此不再赘述。
参考文献:[1] 钟嶷等. 自然沉降法和撞击法在空气细菌总数测定中的应用和比较. 环境与健康杂志. 2004.5, Vol 21(5).
来源:“一起食安行”公众号,(作者:银蛇郎君),内容版权归原作者所有。
说明:文章、视频、图片等所有内容,仅用于学习交流,若有侵权内容及其他涉法内容,请及时联系删除或修改,特此声明。

